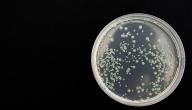

محتويات
الغازات
الغازات هي ناتج طبيعي لعملية هضم الطعام في الجهاز الهضمي، وعادةً ما يتخلص الجسم من الغازات من خلال الفم عن طريق التجشؤ أو من خلال فتحة الشرج عن طريق إخراج الريح، وعادةً ما يحدث ذلك 20 مرةً في اليوم، وتنتج الغازات في الجسم بطريقتين؛ إمّا من خلال ابتلاع الهواء عند تناول الطعام والشراب، وإمّا عن طريق البكتيريا الموجودة في الأمعاء الغليظة التي تحطم الطعام، إذ ينتقل الطعام غير المهضوم من الأمعاء الدقيقة إلى الأمعاء الغليظة، وبمجرد وصوله تقوم هذه البكتيريا بتحطيمه وإنتاج الغازات.[١] قد تشير الغازات الزائدة في الجسم في بعض الحالات إلى وجود اضطرابات في الجهاز الهضمي، لكن في العديد من الحالات تكون زيادتها أمرًا عرضيًا طبيعيًا.[٢]
10 أطعمة تزيد من الغازات
إنّ إجراء تغييرات في النظام الغذائي يساهم في التخلص من الغازات، ويُذكر في ما يأتي 10 أطعمة تزيد من الغازات يجب تجنبها للتخلص من النفخة:[٣]
- البقوليات: توجد البقوليات على رأس قائمة الأطعمة التي تزيد من الغازات في الجسم، وقد يرجع ذلك إلى احتوائها على كميات كبيرة من مركب الرافينوز، وهو سكّر معقد يصعب على الجسم هضمه، إذ يمر الرافينوز عبر الأمعاء الدقيقة إلى الأمعاء الغليظة تقوم البكتيريا بتكسيره، مما يؤدي إلى إطلاق الهيدروجين وثاني أكسيد الكربون وغاز الميثان، ثم تخرج هذه الغازات من الجسم عبر المستقيم، ويمكن التخفيف من قدرة البقوليات على زيادة الغازات من خلال نقعها طوال الليل.
- منتجات الألبان: يحتوي الحليب ومعظم منتجات الألبان بما في ذلك الجبن والبوظة على سكر اللاكتوز، الذي قد يصعب هضمه عند الأشخاص الذين يعانون من نقص في إنزيم يُسمى اللاكتيز، وهو حالة تُعرف باسم عدم تحمل اللاكتوز، وتُعدّ زيادة الغازات في الجسم من أهم أعراض هذه الحالة، ولتقليل الغازات الناتجة عن عدم تحمل اللاكتوز يمكن استخدام بدائل غير الألبان، مثل: حليب اللوز، أو منتجات حليب الصويا، أو تناول أقراص تحتوي على إنزيم اللاكتيز قبل تناول الأطعمة التي تحتوي على اللاكتوز.
- الحبوب الكاملة: تحتوي الحبوب الكاملة مثل القمح والشوفان على الألياف الغذائية والرافينوز والنشا، وجميع هذه المواد يمكن أن تتكسر بواسطة البكتيريا في الأمعاء الغليظة، مما يؤدي إلى إنتاج الغازات، ومن الجدير بالذكر أن الأرز الوحيد من الحبوب لا يزيد إنتاج الغازات.
- الخضروات: من المتعارف عليه أن بعض الخضروات مثل كرنب بروكسل والبروكلي والملفوف والهليون والقرنبيط تسبب زيادة الغازات، فهي كالبقوليات تحتوي على السكر المركب الرافينوز، وعلى الرغم من أن هذه الخضروات قد تسبب الغازات إلا أنها صحية للغاية، لذلك لا بد من استشارة الطبيب قبل إزالتها من النظام الغذائي.
- الصودا: الصودا والمشروبات الغازية الأخرى تضيف نسبةً كبيرةً من الهواء المبتلع، إذ يدخل هذا الهواء إلى الجهاز الهضمي، ويتسبب بزيادة الغازات، مما يسبب التجشؤ، وقد يزيد أيضًا من كمية الغازات التي تخرج من الجسم عبر الريح، ويمكن استبدال الصودا بالعصائر الطبيعية والشاي للتخلص من مشكلة الغازات.
- الفواكه: تحتوي بعض الفواكه مثل التفاح والخوخ والكمثرى على سكر الكحول الطبيعي الذي يُعرف بالسوربيتول، وقد يواجه الجسم صعوبةً في هضم هذا السكر، بالإضافة إلى ذلك تحتوي العديد من الفواكه على ألياف غذائية قابلة للذوبان في الماء، وعند تناولها يجب أن يمر السوربيتول والألياف القابلة للذوبان عبر الأمعاء الغليظة، إذ تقوم البكتيريا بتكسيرها لإنتاج الهيدروجين وثاني أكسيد الكربون وغاز الميثان، وهذا يساهم في زيادة الغازات.
- الحلوى الصلبة: إنّ مصّ الحلوى الصلبة قد يؤدي إلى ابتلاع كمية هواء إضافية، كما يستخدم في العديد من أنواع هذه الحلوى السوربيتول كمُحلٍّ، ويساهم هذان العاملان في زيادة الغازات في الجسم.
- البصل: يحتوي البصل على سكر طبيعي يُسمى الفركتوز، وقد يساهم هذا السكر في زيادة الغازات في الجسم، وذلك عندما تقوم البكتيريا في الأمعاء الغليظة بتحطيمه وإنتاج الغازات.
- مضغ العلكة: على الرغم من أنّ العديد من الأشخاص يرون أنّ العلكة مصدر غير محتمل للغازات، إلا أنّ مضغها قد يزيد من الهواء الذي يبتلعه الشخص، كما أن العديد من أنواعها الخالية من السكر تُحلّى باستخدام كحول السكر الذي يصعب هضمه في الجسم، مثل: السوربيتول، والمانيتول، والإكسليتول، وهذا يساهم أيضًا في إنتاج الغازات، لذلك عادةً ما يوصي الطبيب بالتوقف عن مضغ العلكة للتخلص من الغازات الزائدة.
- الأطعمة المصنعة: تحتوي هذه الأطعمة على مجموعة متنوعة من المكونات، بما في ذلك الفركتوز واللاكتوز، وهما يساهمان في زيادة الغازات في الجسم.
لماذا يزيد إنتاج الغازات؟
تحدث زيادة إنتاج الغازات في الجسم نتيجة أسباب عدة، بما في ذلك ابتلاع كمية من الهواء أكبر من المعتاد، أو الإفراط في تناول الطعام، أو التدخين، أو مضغ العلكة، كما يمكن أن يكون سبب حدوث ذلك تناول كمية كبيرة من الأطعمة التي تزيد الغازات المذكورة أعلاه، أو عدم القدرة على هضم بعض أنواع الأطعمة بصورة كاملة، أو نتيجة تعطل البكتيريا التي توجد عادةً في القولون.
بالإضافة إلى ذلك قد يكون سبب النفخة وزيادة الغازات في الجسم الإصابة ببعض المشكلات الصحية والاضطرابات، بما في ذلك ما يأتي:[٢]
- التهاب البنكرياس المناعي الذاتي.
- الداء البطني، الذي يُعرف أيضًا باعتلال الأمعاء التحسسي تجاه الغلوتين.
- مرض كرون، وهو نوع من أمراض الأمعاء الالتهابية.
- داء السكري.
- متلازمة الإغراق.
- اضطرابات الأكل.
- مرض الارتداد المعدي المريئي.
- خزل المعدة، وهو حالة يحدث فيها خلل في طريقة عمل عضلات جدار المعدة، مما يؤثر على عملية الهضم في الجسم.
- مرض التهاب الأمعاء.
- الانسداد المعوي.
- متلازمة القولون العصبي.
- عدم تحمل اللاكتوز.
- القرحة الهضمية.
- التهاب القولون التقرحي.
ما هي الأطعمة التي تقلل من الغازات؟
في معظم الحالات يُعدّ تجنب الأطعمة التي تزيد من الغازات -والتي ذكرت أعلاه- أو التقليل منها من أكثر الطرق فعاليةً للتخلص من الغازات الزائدة في الجسم، ومع ذلك قد تساعد أنواع أطعمة أخرى على التقليل منها، تتضمن ما يأتي:[٤]
- اللحوم الخالية من الدهون والبروتينات.
- خل التفاح.
- شاي البابونج.
- البيض.
- السمك.
- بعض الخضروات، مثل: الخس، والكوسا.
- بعض الفواكه، مثل: الطماطم، والعنب، والبطيخ.
- الأرز.
- شاي النعناع.
- مكملات زيت النعناع، فقد أشارت دراسة أجريت عام 2014 إلى أنّ هذه المكملات قد تساهم في السيطرة على أعراض متلازمة القولون العصبي، بما في ذلك النفخة والغازات.[٥]
المراجع
- ↑ Minesh Khatri, MD (15-2-2020), "The Digestive System and Gas"، webmd, Retrieved 16-5-200. Edited.
- ^ أ ب Mayo Clinic Staff (16-4-2019), "Intestinal gas"، mayoclinic, Retrieved 16-5-2020. Edited.
- ↑ Rena Goldman (20-1-2015), "10 Foods That Cause Gas"، healthline, Retrieved 15-5-2020. Edited.
- ↑ Jenna Fletcher (25-10-2018), "Which foods cause gas and bloating?"، medicalnewstoday, Retrieved 16-5-2020. Edited.
- ↑ Khanna R1, MacDonald JK, Levesque BG. (7-2014), "Peppermint oil for the treatment of irritable bowel syndrome: a systematic review and meta-analysis.", J Clin Gastroenterol., Issue 48, Folder 6, Page 505-512. Edited.